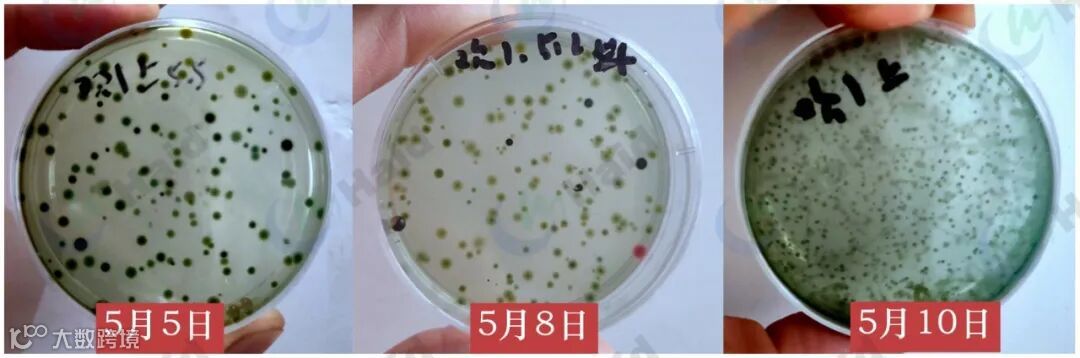
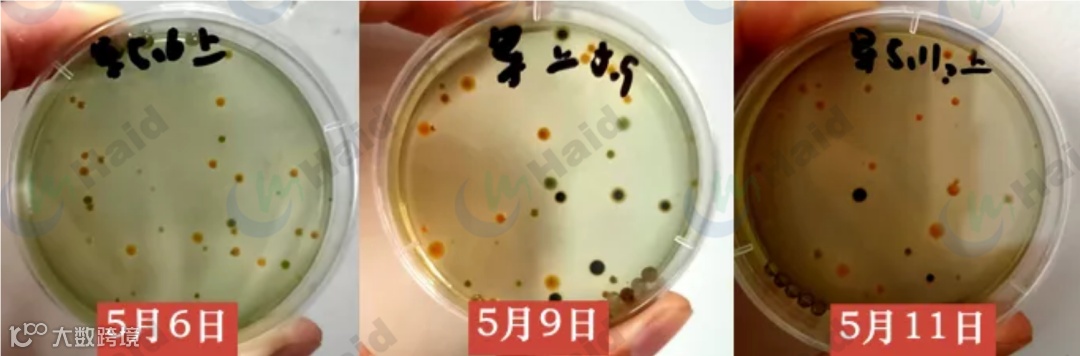
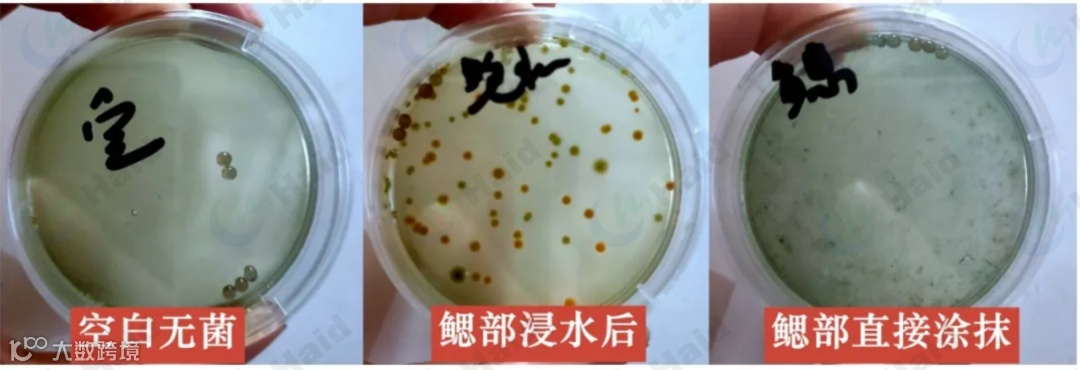
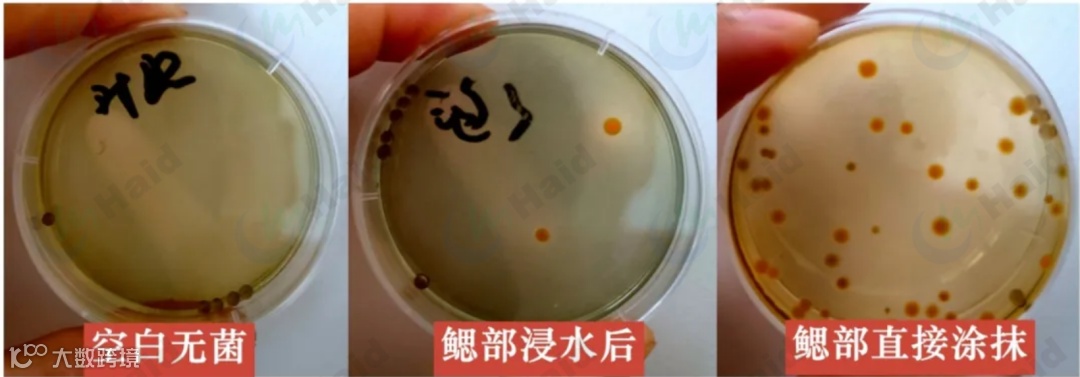
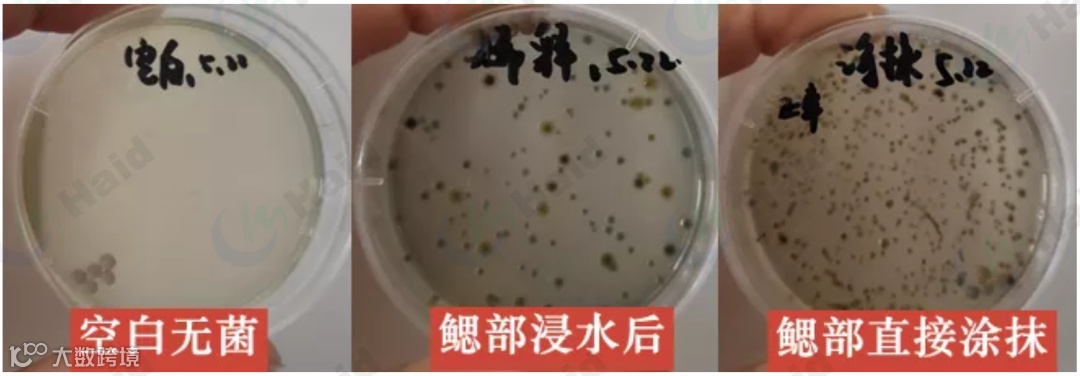

文 | 图 广州容川 袁瑞鹏 孙会强 动保事业部 梁乾坤 黄徐林
5月5日-9日,珠海爆发了惨烈的“百塘游水”,市面上近半成的海鲈新鱼塘都在游水。
一、海鲈游水,“老大难” !
提到海鲈养殖,游水是避不开的一个话题。究竟什么是游水呢?简单来说“游水”就是海鲈浮头。由于游水在海鲈养殖中实在太常见,更有养户打趣自嘲“不游水的海鲈长不大”。每年进入5月份立夏前后都是海鲈游水高发期,而今年更是如此。

5月5日-9日,珠海更是爆发了惨烈的“百塘游水”,市面上近半成的海鲈新鱼塘都在游水。而一旦游水,不仅处理游水需要花费财力,游水后的损耗、停喂、减料,更是会影响海鲈养户抢头批的进程。

那么为什么每年5月立夏前后都会爆发大规模游水?如何避免海鲈“游水”、减少海鲈“游水”及“游水”后的损耗,都成为了海鲈养殖户急切关注的技术问题。今天我们来为大家一一解答。
二、 5月立夏前后,为什么易大规模游水?
01
溶氧降低导致游水
水温的持续升高
海鲈养殖户都知道,水温18-27℃时候的海鲈是最好养的,而进入5月后水温由四月底的25℃逐渐升高到30℃,温度的持续上升使海鲈塘水中溶解氧变低,海鲈生存环境变得恶劣,比低温时更容易发生应激反应。

气压的持续降低
进入5月后,大气压由原来的1017hpa降低到1002hpa,一周内降低了15hpa,空气持续闷热、潮湿。

气压的持续降低,水温的连续升高,导致海鲈生存环境变差,最终作用到池塘中,就是池塘溶氧的持续降低。借助海大渔家慧智慧溶氧检测系统,我们可以可以看到在气压持续降低的6天时间里,池塘溶氧从最高9.2mg/L,降低到最高6.3mg/L,溶氧平均降低3mg/L,也就是在气压和溶氧双低的5月5日-9日,珠海海鲈新鱼发生了“百塘游水”,让海鲈养户苦不堪言。

02
池塘寄生虫、有害菌滋生易导致游水
当海鲈体内有指环虫、斜管虫、车轮虫等多寄生在鳃部的寄生虫时,会对海鲈鳃部造成损害,影响海鲈的氧气交换。在池塘溶氧持续降低情况下,往往寄生虫较多的塘口先发生游水,且易反复游水。

池塘中有害菌的数量也是导致海鲈游水的关键因素。对塘口的嗜水气单胞菌动态监测发现,进入5月,容易反复游水的塘口其水中嗜水气单胞菌一直保持较高水平,而且存在加料困难情况。
而在5月加料较稳定,游水较少且游水损耗较少塘口,池塘中嗜水气单胞菌数量一直维持在一个较低水平。
对游水海鲈未消毒前的游水鱼鳃片进行嗜水气单胞菌平板涂板,分别为一滴矿泉水,使用矿泉水浸泡搅匀2分钟后(0.25g鱼鳃片+6.5g矿泉水)涂片,直接取鳃片进行涂片。可以看到游水鱼鳃部滋生了大量的嗜水气单胞菌,鳃片直接涂抹的平板直接长满了嗜水气单胞菌。
对使用杀虫药+菌速清5h后的游水鱼进行涂片,结果如下。可以看到无论是浸水搅拌还是直接涂抹,嗜水气单胞菌数量已经大大降低。配合202+粒粒氧,此时已经有很多游水鱼沉了下去。
综上可以看出游水与嗜水气单胞菌呈现一定的关联性,而强消毒、杀虫类产品之所以能压制游水可能与消灭或减少了水体和鱼体的嗜水气单胞菌有关。

其他塘口未游水鱼鳃片(无寄生虫)进行涂板
其他塘口未游水鱼鳃片(指环虫寄生)进行涂板
由上可以看出,鱼鳃有指环虫寄生的海鲈,鱼鳃中嗜水气单胞菌数量远高于没有寄生虫的海鲈。可以认为池塘中嗜水气单胞菌滋生与寄生虫呈现正相关,可能是寄生虫使鳃部出现损伤为嗜水气单胞菌的滋生提供了条件,而嗜水气单胞菌的大量滋生又导致了鳃部出血严重,大量游水。

03
体质差、肝肠问题导致游水

三、小 结
1、寄生虫寄生海鲈易导致海鲈游水,建议每隔1-2周定期查虫、杀虫。
2、池塘中嗜水气单胞菌大量滋生可能会导致海鲈游水,建议定期改底消毒,抑制有害菌滋生。
3、气压降低和水温升高会导致池塘溶氧降低,建议在气压持续降低超过5hpa时采取增氧措施。
4、海鲈肝肠差易爆发急性肠胃炎游水,建议定期护理肝肠。
那么是否我们对海鲈游水就束手无策了呢?后面又该如何避免海鲈“游水”、减少海鲈“游水”发生后的损耗呢?
请关注下篇
《海鲈游水频发,我们需要这样做!》
海大农牧
接地气的水产一线技术
长摁二维码,即刻关注

